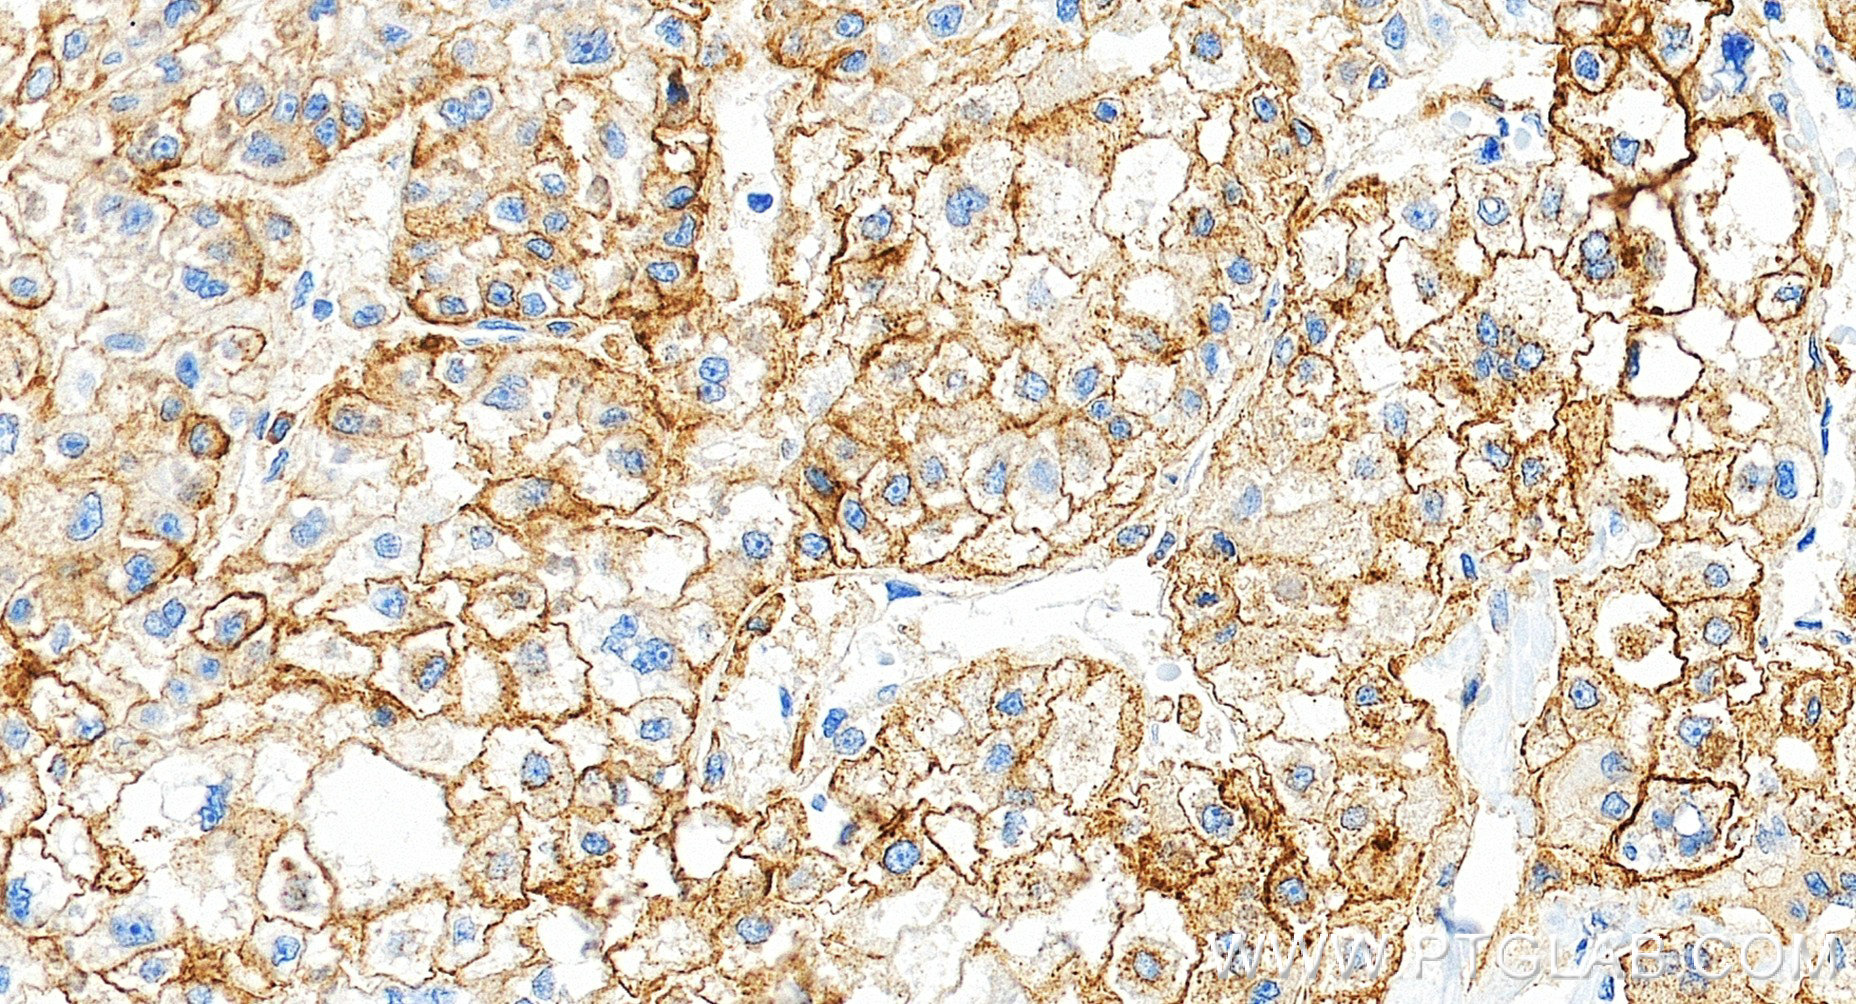

验证数据展示
产品信息
81793-13-PBS targets CD71 in IHC, Indirect ELISA applications and shows reactivity with human samples.
| 经测试应用 | IHC, Indirect ELISA Application Description |
| 经测试反应性 | human |
| 免疫原 |
CatNo: Eg0339 Product name: Recombinant Human Transferrin R/CD71 protein (His Tag) Source: mammalian cells-derived, pHZ-KIsec-C-6*HIS Tag: N-6*HIS Sequence: CKGVEPKTECERLAGTESPVREEPGEDFPAARRLYWDDLKRKLSEKLDSTDFTSTIKLLNENSYVPREAGSQKDENLALYVENQFREFKLSKVWRDQHFVKIQVKDSAQNSVIIVDKNGRLVYLVENPGGYVAYSKAATVTGKLVHANFGTKKDFEDLYTPVNGSIVIVRAGKITFAEKVANAESLNAIGVLIYMDQTKFPIVNAELSFFGHAHLGTGDPYTPGFPSFNHTQFPPSRSSGLPNIPVQTISRAAAEKLFGNMEGDCPSDWKTDSTCRMVTSESKNVKLTVSNVLKEIKILNIFGVIKGFVEPDHYVVVGAQRDAWGPGAAKSGVGTALLLKLAQMFSDMVLKDGFQPSRSIIFASWSAGDFGSVGATEWLEGYLSSLHLKAFTYINLDKAVLGTSNFKVSASPLLYTLIEKTMQNVKHPVTGQFLYQDSNWASKVEKLTLDNAAFPFLAYSGIPAVSFCFCEDTDYPYLGTTMDTYKELIERIPELNKVARAAAEVAGQFVIKLTHDVELNLDYERYNSQLLSFVRDLNQYRADIKEMGLSLQWLYSARGDFFRATSRLTTDFGNAEKTDRFVMKKLNDRVMRVEYHFLSPYVSPKESPFRHVFWGSGSHTLPALLENLKLRKQNNGAFNETLFRNQLALATWTIQGAANALSGDVWDIDNEF 种属同源性预测 |
| 宿主/亚型 | Rabbit / IgG |
| 抗体类别 | Recombinant |
| 产品类型 | Antibody |
| 全称 | transferrin receptor (p90, CD71) |
| 别名 | p90, sTfR, T9, TFR, TFR1 |
| 计算分子量 | 85 kDa |
| 基因名称 | CD71 |
| Gene ID (NCBI) | 7037 |
| ENSEMBL Gene ID | ENSG00000072274 |
| 偶联类型 | Unconjugated |
| 形式 | Liquid |
| 纯化方式 | Protein A purification |
| UNIPROT ID | P02786 |
| 储存缓冲液 | PBS only, pH 7.3. |
| 储存条件 | Store at -80°C. The product is shipped with ice packs. Upon receipt, store it immediately at -80°C |
背景介绍
CD71, also known as transferrin receptor protein 1 (TfR1), is a transmembrane glycoprotein composed of two disulfide-linked monomers, each of 90 kDa molecular weight. Each monomer binds one holo-transferrin molecule creating an iron-Tf-TfR complex that enters the cell by endocytosis. CD71 is present on actively proliferating cells and is essential for iron transport into proliferating cells.